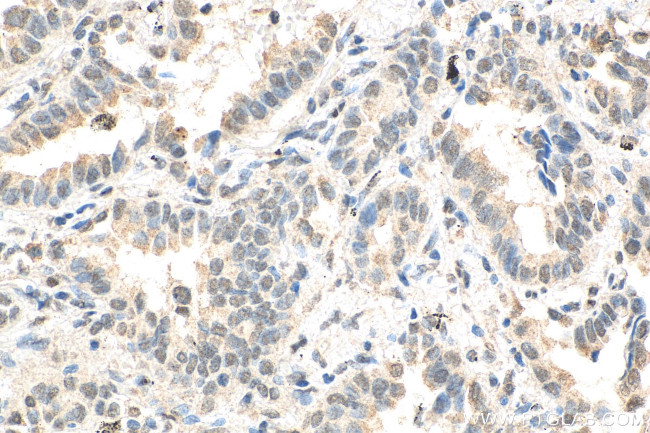
ID1 Antibody in Immunohistochemistry (Paraffin) (IHC (P))

Search
Proteintech
ID1 Monoclonal Antibody (1H3G11)
{{$productOrderCtrl.translations['antibody.pdp.commerceCard.promotion.promotions']}}
{{$productOrderCtrl.translations['antibody.pdp.commerceCard.promotion.viewpromo']}}
{{$productOrderCtrl.translations['antibody.pdp.commerceCard.promotion.promocode']}}: {{promo.promoCode}} {{promo.promoTitle}} {{promo.promoDescription}}. {{$productOrderCtrl.translations['antibody.pdp.commerceCard.promotion.learnmore']}}
产品信息
67827-1-IG
种属反应
宿主/亚型
分类
类型
克隆号
抗原
偶联物
形式
浓度
纯化类型
保存液
内含物
保存条件
运输条件
产品详细信息
Aliquoting is unnecessary for -20°C storage.
靶标信息
ID1 is a helix-loop-helix (HLH) protein that can form heterodimers with members of the basic HLH family of transcription factors. It has no DNA binding activity and therefore can inhibit the DNA binding and transcriptional activation ability of basic HLH proteins with which it interacts. This protein may play a role in cell growth, senescence, and differentiation. Two transcript variants encoding different isoforms have been found for this gene.The protein encoded by this gene is a helix-loop-helix (HLH) protein that can form heterodimers with members of the basic HLH family of transcription factors. The encoded protein has no DNA binding activity and therefore can inhibit the DNA binding and transcriptional activation ability of basic HLH proteins with which it interacts. This protein may play a role in cell growth, senescence, and differentiation. Two transcript variants encoding different isoforms have been found for this gene.
仅用于科研。不用于诊断过程。未经明确授权不得转售。
生物信息学
蛋白别名: bHLHb24; Class B basic helix-loop-helix protein 24; dJ857M17.1.2; dJ857M17.1.2 (inhibitor of DNA binding 1, dominant negative helix-loop-helix protein); DNA-binding protein inhibitor ID-1; Inhibitor of differentiation 1; Inhibitor of DNA binding 1; Inhibitor of DNA binding 1 helix-loop-helix protein (splice varaiation); inhibitor of DNA binding 1, dominant negative helix-loop-helix protein; Inhibitor of DNA binding 1, helix-loop-helix protein (splice variation)
基因别名: AI323524; BHLHB24; D2Wsu140e; ID; Id-1; ID1; ID125A; Idb1
UniProt ID: (Human) P41134, (Rat) P41135
Entrez Gene ID: (Human) 3397, (Rat) 25261, (Mouse) 15901